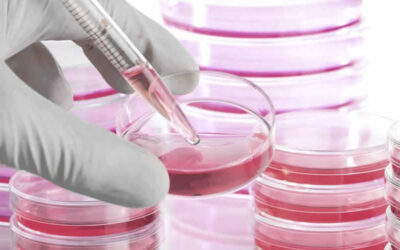

Científicos de Cuba y EEUU abordan en congreso avances en células madre
LA HABANA.- Cerca de un centenar de investigadores de Cuba y más de 70 especialistas de EEUU debatirán hoy y mañana durante el Primer Intercambio Interamericano de Células Madre, con sede en La Habana, en el que participan también expertos de otros países, informan medios oficiales de la isla. Además de mostrar los avances de...